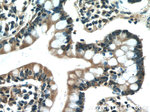
IL31 Antibody in Immunohistochemistry (Paraffin) (IHC (P))

Search
Proteintech
IL31 Polyclonal Antibody
{{$productOrderCtrl.translations['antibody.pdp.commerceCard.promotion.promotions']}}
{{$productOrderCtrl.translations['antibody.pdp.commerceCard.promotion.viewpromo']}}
{{$productOrderCtrl.translations['antibody.pdp.commerceCard.promotion.promocode']}}: {{promo.promoCode}} {{promo.promoTitle}} {{promo.promoDescription}}. {{$productOrderCtrl.translations['antibody.pdp.commerceCard.promotion.learnmore']}}
产品信息
22859-1-AP
种属反应
已发表种属
宿主/亚型
分类
类型
抗原
偶联物
形式
浓度
规格
纯化类型
保存液
内含物
保存条件
运输条件
产品详细信息
Immunogen sequence: RLLRPSDDV QKIVEELQSL SKMLLKDVEE EKGVLVSQNY TLPCLSPDAQ PPNNIHSPAI RAYLKTIRQL DNKSVIDEII EHLDKLIFQD APETNISVPT DTHECKRFIL TISQQFSECM DLALKSLTSG AQQATT (30-164 aa encoded by BC132998)
靶标信息
Interleukin-31 (IL-31) is a recently discovered T-cell cytokine closely related to IL-6 type cytokines and is preferentially produced by T helper type 2 cells. IL-31 activity is mediated through the ligand-induced oligomerization of a dimeric receptor complex containing IL-31 receptor A and oncostatin M receptor. In response to IL-31 binding, these proteins activate the JAK/STAT and the AKT signaling pathways. RNA levels of IL-31 receptor A and oncostatin M receptor are induced in activated monocytes but are expressed constitutively in epithelial cells. IL-31, when overexpressed in transgenic mice, results in the development of pruritis, alopecia, and skin lesions and in humans may result in atopic dermatitis, suggesting that IL-31 may represent a novel target for antipruritic drug development.
仅用于科研。不用于诊断过程。未经明确授权不得转售。
生物信息学
蛋白别名: four helical bundle cytokine; IL-31; ILN; Interleukin; Interleukin-31
基因别名: IL-31; IL31
UniProt ID: (Human) Q6EBC2
Entrez Gene ID: (Human) 386653